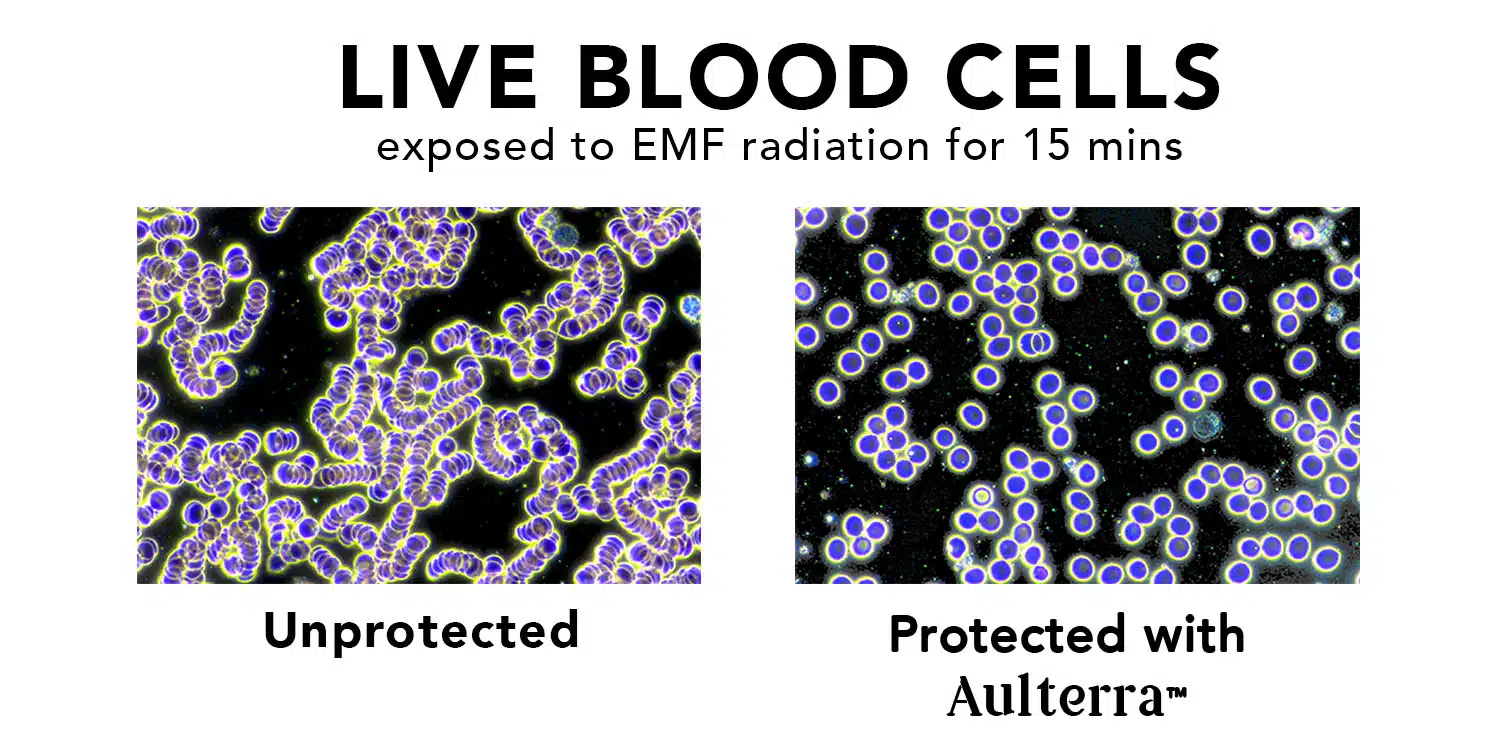
Live blood cells

Science & Testing
How Aulterra products are tested for measurable change, disc construction, and signal-safe performance.
Measured change
The visual and instrument-based evidence below is used to demonstrate measurable change in biological and electromagnetic response after protection is applied.
Live blood cells
Unprotected vs protected after exposure

Signal spectrum test
Without Neutralizer vs with Neutralizer

Fingerprint field image
Before vs after application
See the Proof
These two demonstrations show live blood analysis examples used to explain the difference between unprotected and protected exposure conditions.
Disc Blood Test
Live blood analysis demonstration for the disc product.
Pendant Blood Test
Live blood analysis demonstration for the pendant product.

Disc construction
Aulterra discs are built around a proprietary paramagnetic mineral blend and a lightweight adhesive format designed for everyday device use.
A proprietary blend of natural activated rare-earth paramagnetic elements.
A stable adhesive layer that allows secure placement on everyday devices.
A lightweight substrate engineered for phones, tablets, laptops, and other electronics.
A compact disc design intended to support neutralisation without blocking signal performance.
How it works
Aulterra products use a proprietary blend of natural paramagnetic elements to retune chaotic man-made EMF patterns, aiming to make them more coherent and biologically compatible without blocking device functionality.
This is why the products are positioned as signal-safe: the goal is neutralisation rather than shielding, so the device can continue to perform as intended.
Learn How Aulterra Technology WorksWhat we measure
We focus on measurable changes such as signal-pattern shifts, blood-analysis demonstrations, and observational testing that illustrate coherence-based change.
What we don't claim
We do not present these products as medical treatment or disease prevention. Customers should always seek professional advice for personal health concerns.
Signal Safe
Doesn't block your device signal
Designed for everyday environments
Works across common phones, tablets, laptops, and wireless devices
Frequently asked questions
Want to learn more about the science?
Explore the biological research background, the work of Dr Pall, and the broader discussion around EMF health concerns.

Extensive Research by Dr Pall
Dr. Martin L. Pall, Ph.D., is Professor Emeritus of Biochemistry and Basic Medical Sciences at Washington State University. His published work is frequently referenced in discussions around the biological effects of EMFs and how those effects may influence the human body.[2]
EMF Health Concerns
Beyond measured changes in coherence, there is a broader body of research into long-term exposure, electromagnetic hypersensitivity (EHS), cellular stress, and the specific concerns often raised for children and highly exposed environments.[1][3]
Explore EMF Health ConcernsReferences
Belpomme, D., Campagnac, C., & Irigaray, P. (2015). Reliable disease biomarkers characterizing and identifying electrohypersensitivity and multiple chemical sensitivity as two etiopathogenic variants of a unique pathological disorder. Reviews on Environmental Health, 30(4), 251-271.
Pall, M.L. (2018). Wi-Fi is an important threat to human health. Environmental Research, 164, 405-416.
Hardell, L., & Carlberg, M. (2019). Mobile phone and cordless phone use and the risk for glioma - analysis of pooled case-control studies in Sweden, 1997-2015. Pathophysiology, 26(2), 121-135.